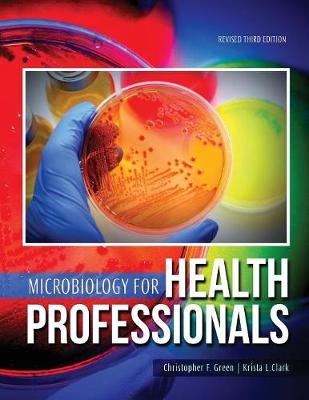
Microbiology for Health Professionals - Krista Clark, Christopher Green

Microbiology for Health Professionals
Seiten
2021
|
3rd Revised edition
Kendall/Hunt Publishing Co ,U.S. (Verlag)
978-1-5249-7873-0 (ISBN)
Kendall/Hunt Publishing Co ,U.S. (Verlag)
978-1-5249-7873-0 (ISBN)
- Titel nicht im Sortiment
- Artikel merken
| Erscheint lt. Verlag | 30.7.2021 |
|---|---|
| Verlagsort | Iowa |
| Sprache | englisch |
| Themenwelt | Medizin / Pharmazie ► Medizinische Fachgebiete ► Mikrobiologie / Infektologie / Reisemedizin |
| ISBN-10 | 1-5249-7873-6 / 1524978736 |
| ISBN-13 | 978-1-5249-7873-0 / 9781524978730 |
| Zustand | Neuware |
| Informationen gemäß Produktsicherheitsverordnung (GPSR) | |
| Haben Sie eine Frage zum Produkt? |
Mehr entdecken
aus dem Bereich
aus dem Bereich
und Erste Hilfe an Bord
Buch | Softcover (2024)
MWV Medizinisch Wissenschaftliche Verlagsgesellschaft
CHF 55,90


